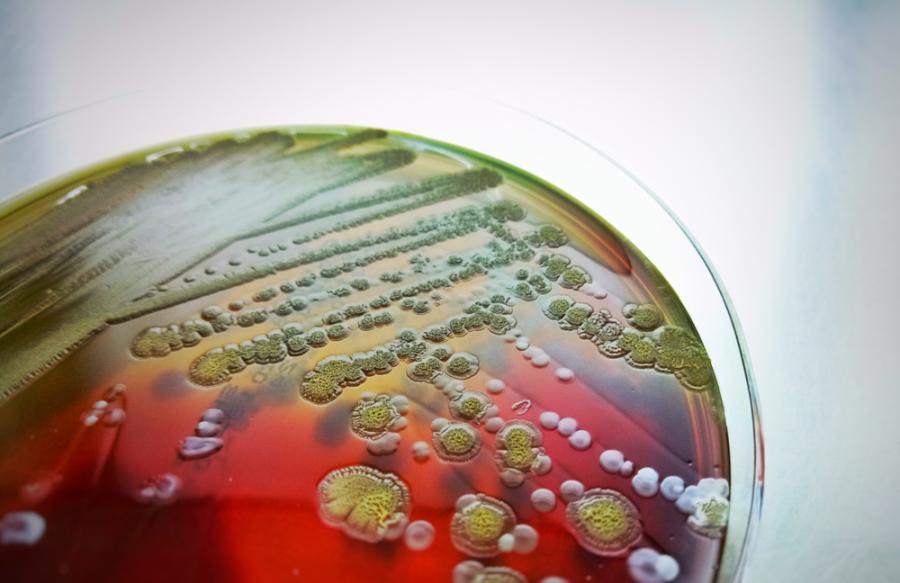
Нов тест показва кои антибиотици действително унищожават опасните бактерии

Нов тест показва кои антибиотици действително унищожават опасните бактерии
Нов лабораторен тест може точно да покаже кои антибиотици реално действат срещу конкретни бактерии, съобщава електронното издание „Юрикалърт“. Методът дава много по-прецизна оценка на ефективността на антибиотичната терапия и може да помогне в борбата с нарастващата антибиотична резистентност.
Иновативен метод, разработен в Базел
Изследването е ръководено от д-р Лукас Бьок от Катедрата по биомедицина в Базелския университет и Университетската болница в Базел. Учените представят новия подход в списание Nature Microbiology, като го описват като значителна стъпка напред в прогнозирането на успеха на антибиотичното лечение.
Методът носи името „антимикробно тестване на единични клетки“ и се основава на микроскопско наблюдение на милиони индивидуални бактерии при хиляди различни експериментални условия.
Как работи антимикробното тестване на единични клетки
„Използваме метода, за да заснемем всяка отделна бактерия в продължение на няколко дни и да наблюдаваме дали и колко бързо лекарството действително я убива“, обяснява д-р Бьок.
По този начин учените могат точно да определят какъв процент от бактериалната популация се елиминира от прилаганата терапия и колко ефективно е дадено лекарство, вместо да разчитат само на индиректни показатели.
Защо досегашните тестове не са достатъчни
В момента антибиотиците се оценяват основно според това доколко потискат растежа на бактериите в лабораторни условия. Това обаче не винаги означава, че те реално унищожават патогените в организма на пациента.
Изключително важен фактор е дали активните вещества действително убиват бактериите, а не просто временно спират тяхното размножаване – нещо, което стандартните тестове често не могат да покажат.
Антибиотичната резистентност – нарастващ глобален проблем
Бактериите, устойчиви на антибиотици, са сред най-сериозните предизвикателства пред съвременното здравеопазване. Поради генетични мутации патогените все по-често развиват резистентност към обичайно използваните лекарства, което значително затруднява лечението на различни инфекции, отбелязва „Юрикалърт“.
Дори когато не са станали напълно резистентни, бактериите понякога могат да „избягват“ действието на антибиотиците, особено ако се намират в латентно състояние. В тези случаи те не се размножават, но и не биват унищожени от лекарствата, което им позволява да се активират отново след прекратяване на терапията.
Значение за лечението на туберкулоза и тежки инфекции
Този проблем е особено критичен при заболявания като туберкулозата и други инфекции, чието лечение продължава месеци. В такива случаи изборът на антибиотици, които реално убиват бактериите и напълно стерилизират инфекцията, е от решаващо значение за успеха на терапията.
Резултати от тестове с туберкулозни бактерии
Изследователският екип от Базелския университет е тествал 65 комбинирани антибиотични терапии върху туберкулозния патоген Mycobacterium tuberculosis. Освен това методът е приложен върху бактериални проби от 400 пациенти с белодробна инфекция, причинена от Mycobacterium abscessus – бактерия, също свързана с туберкулозния патоген.
Антибиотична толерантност и генетични различия
Учените наблюдават значителни вариации както между различните терапевтични комбинации, така и между бактериалните щамове при отделните пациенти. Те наричат този феномен „антибиотична толерантност“.
Анализите показват, че определени генетични характеристики на бактериите определят доколко те могат да „издържат“ на антибиотичното лечение, без да бъдат напълно унищожени.
„Колкото по-добре бактериите понасят антибиотик, толкова по-малки са шансовете за терапевтичен успех при пациентите“, обобщава д-р Лукас Бьок.
Потенциал за персонализирана антибиотична терапия
В сравнение с данни от клинични проучвания и животински модели, резултатите от антимикробните тестове на единични клетки дават изключително точна представа за това колко ефективно различните терапевтични средства елиминират инфекциите, се казва в публикацията.
Засега методът се използва основно като изследователски инструмент, но в бъдеще може да намери приложение както в клиничната практика, така и във фармацевтичната индустрия.
Ползи за пациентите и разработването на нови лекарства
Според д-р Бьок новият тест има потенциала да бъде от полза както за пациентите, така и за разработването на нови медикаменти.
„Нашият метод за тестване ни позволява да адаптираме антибиотичната терапия специално към бактериалните щамове при отделните пациенти“, подчертава той. „Не на последно място, събраните данни могат да помогнат на учените да разберат по-добре стратегиите за оцеляване на патогените и да положат основите за нови, по-ефективни терапевтични подходи“, допълва изследователят от Базелския университет.